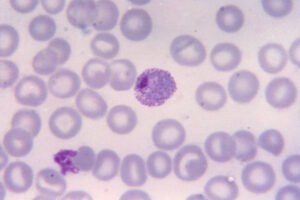
Comment se produit la respiration cellulaire?

Que sont les technologies d'assistance
Lorsque nous parlons de la technologie d'assistance, nous nous référons aux appareils et services utilisés...
Actualités
État de résultat: ce que c'est
Lorsque nous parlons du compte de résultat, une référence est faite à l'un des trois rapports financiers...
Qui est comptable
Lorsque nous parlons de «comptable», nous nous référons à un expert en comptabilité, qui réalise souvent son activité de profession...
Qu'est-ce qu'un plan d'affaires
Un plan d'affaires est un document qui rapporte précisément quels sont les objectifs d'une entreprise et...
Biologie: explication
La biologie est cette science qui étudie les composantes naturelles et les êtres vivants. C'est un champ très vaste qui découle...
Le maître laisse une marque sur l'éternité; Vous ne pouvez jamais savoir quand son influence s'arrêtera.
Henry Adams
De nos jours, de nombreuses...
Pourquoi choisir l'ingénierie
Il y a beaucoup d'étudiants qui se demandent si la Faculté d'ingénierie est le bon choix au niveau de...
Comment pouvez-vous trouver du travail dans une école italienne pour les étrangers?
Si votre objectif est de travailler en tant que professeur italien pour...
Qu'est-ce que la respiration cellulaire
Par «respiration cellulaire» signifie que le processus spécifique par lequel certaines molécules biologiques...
Quelle est la différence entre le complément direct et le complément indirect?
Lors de l'étude de la grammaire italienne, l'une des distinctions...